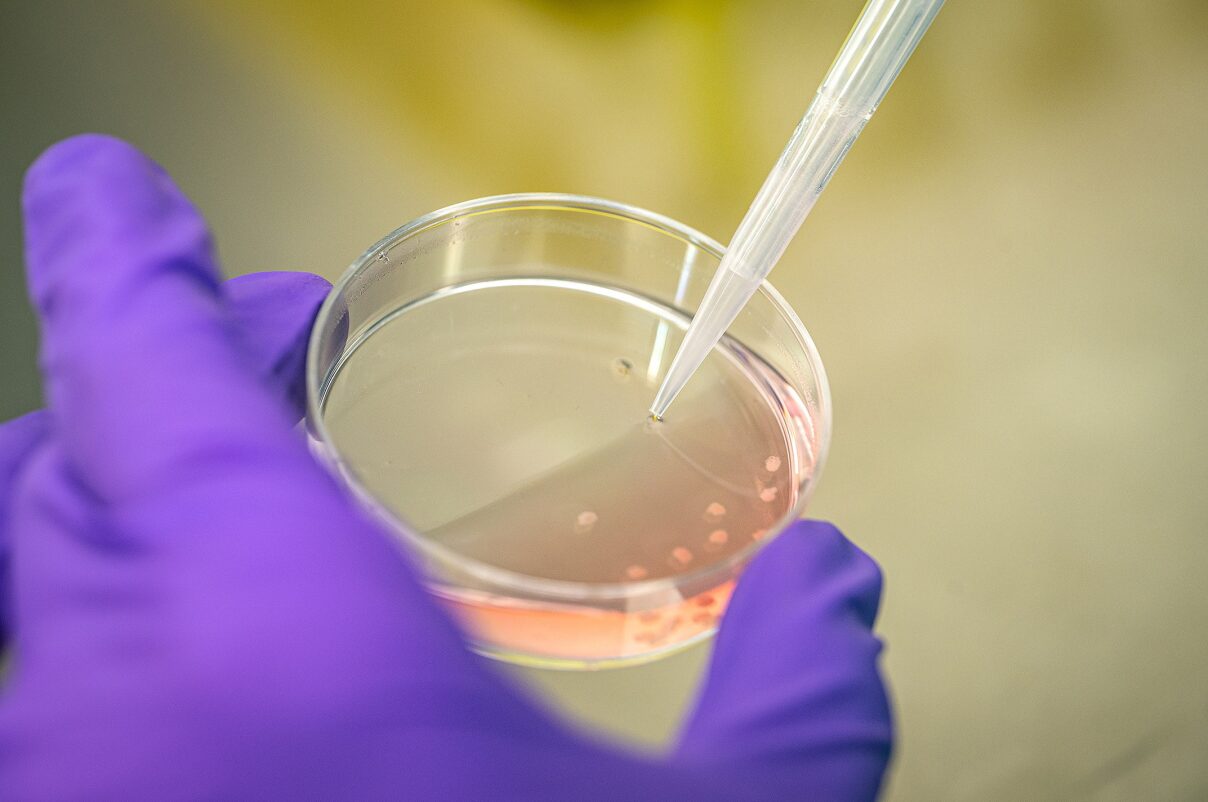

Currently, the processes of developing new drugs and matching them to patients are suboptimal. Many therapeutics that could be effective for certain patients are not prescribed to them, while many drugs that are ineffective for individual patients are prescribed. Additionally, numerous new drug candidates fail after a costly development process because they are based on preclinical models that do not accurately reflect human disease conditions.
This gap between experimental settings and patient conditions reduces the success rate of drug development, thereby lowering the number of new drug candidates that reach the market. This is costly in terms of both human health and economic value. The Regenerative Medicine Center Utrecht is addressing these issues by developing new models and approaches to simulate human diseases in the lab, aiming to resolve these challenges incrementally.
Averages can be calculated, but do not exist in real life
Connecting the average outcomes of the treatment population to an individual patient in the consultation room remains a challenging step. The efficacy and safety of drugs are measured as averages at the population level, but these averages do not accurately represent the individual for whom the medication is intended.
This means that in practice you start with a medicine which works on average the best on the population level, and from which the chance that an individual may benefit is the highest. However, its true effectiveness for that individual still needs to be tested. If the initial drug proves ineffective, the next step is to switch to another medication, hoping to find a suitable treatment as quickly as possible. Conversely, if the initial drug works, you might not test another drug that, while less effective on average, could potentially be better suited for the individual.
The inability to accurately assess whether a treatment works for an individual results in prolonged uncertainty for patients, allowing diseases to progress and potentially cause new complications from the side effects of ineffective treatments. This situation places additional strain on the already overburdened healthcare system, making it inefficient and unnecessarily costly.
Therefore, individuals should not be the average
Matching medicines to individuals is crucial not only for existing treatments but also for drugs in development. Currently, developing a new drug takes about 10 years and costs around a billion euros. Laboratory studies precede trials in increasingly larger groups of patients, functioning as a filtering process to identify drugs where the beneficial effects outweigh the unfavorable side effects. However, this entire process is based on population averages.
Failures along this process can often be attributed to test methods that do not sufficiently replicate the disease in the patient, incorrect measurement of clinical outcomes, or other factors. These errors frequently stem from reliance on population averages rather than determining what specifically works for each individual.
Going beyond the average, using an Utrecht invention
The discovery of organoids by the research group led by Hans Clevers in Utrecht in the early 2000s is credited with catalyzing significant advancements in the drug development process. These three-dimensional mini-organs, created from adult-specific stem cells, closely mimic the structure and function of the organs they originate from. While initial breakthroughs were made with intestinal organoids, today there are organoid equivalents for various tissues including kidney, liver, skin, brain, lung, eyes, and many others.
Organoids have opened up new avenues for studying tissues in detail under more controlled conditions than with animal models. By deriving organoids from various individuals, it is now feasible to conduct large-scale comparisons between healthy and diseased tissues in laboratory settings. However, the impact of organoids extends beyond research models. Jeffrey Beekman, professor of Cellular Disease Models at UMC Utrecht, has successfully demonstrated the potential of organoids in disease diagnosis and treatment.
Organoids can bridge laboratory and clinical worlds
In current drug research, the laboratory and clinical phases operate as distinct realms. In laboratories, hundreds of thousands to millions of substances undergo testing to assess their impact on biological processes. Compounds showing promise advance through increasingly sophisticated models designed to mimic human disease processes more accurately. The most promising candidates undergo animal testing to evaluate potential positive and negative effects in whole organisms.
“The quality of the preclinical phase hinges directly on the laboratory models employed,” explains Beekman. “The challenge lies in ensuring that results from lab tests truly correlate with the intended outcomes in humans. While current artificial cell models excel in scalability, they often fall short in representativeness. Complex models and animal studies also face challenges, as their translation to human outcomes is frequently unclear or non-existent, alongside ethical concerns about animal use.”
Patient cells present an intriguing option, especially when the molecular target of a drug is known, allowing direct study in living patient cells. However, difficulties in growing patient cells have historically limited their utility. Organoids represent a transformative advancement in this regard. They can be cultivated on a large scale and encompass multiple cell types, thereby enhancing their resemblance to human biology compared to other cell models. The significance of these advancements is underscored by ongoing research at UMC Utrecht, particularly in the study of Cystic Fibrosis.
Case in point: making sense of Cystic Fibrosis
Cystic Fibrosis (CF) is a rare inherited condition caused by a genetic variation that affects mucus membranes throughout the body. This variation impacts the CFTR gene, responsible for an ion exchange channel, which when malfunctioning, reduces water content in mucus, resulting in thick and tough secretions. CF primarily affects the airways, digestive tract, and pancreas, and if untreated, it can be life-threatening. The complexity of CF arises from over 2000 different variants of the CFTR gene, leading to varying levels of severity and challenges in finding universal treatment options.
Beekman and his team observed distinct behavior in intestinal organoids derived from CF patients compared to those from healthy individuals. “Intestinal organoids are essentially hollow spheres where the CFTR channel regulates ion and water exchange into the lumen,” Beekman explains. “We found that CF patient-derived organoids either do not swell or exhibit significantly reduced swelling compared to healthy organoids. This discovery led to the development of the Forskolin-induced Swelling (FIS) test, which measures organoid swelling as an indicator of CF severity.”
“We found that CF patient-derived organoids either do not swell or exhibit significantly reduced swelling compared to healthy organoids. This discovery led to the development of the Forskolin-induced Swelling (FIS) test, which measures organoid swelling as an indicator of CF severity.”
From discovery to fully developed diagnostic model
Beekman: ‘We then demonstrated that we can precisely measure this individual CFTR component of the disease on a large scale in the laboratory and showed that the defect of cystic fibrosis could be repaired with chemical compounds and CRISPR-Cas9 techniques. Additionally, we demonstrated that measurements in the mini intestines could be used for diagnostics, prediction of disease development, and prediction of whether certain drugs will be effective.’ This organoid model has contributed greatly to the development of treatments for people with cystic fibrosis.
Recently, the medicine ‘Kaftrio’ became available for the most common varieties of CF, and it offers a good treatment option for approximately ninety percent of the patient population, increasing their life expectancy significantly. But the organoids also offer hope for the remaining ten percent.
Beekman explains this: ‘With our successful model we can test drugs in a patient-specific organoid, and then choose the treatment that fits this person best.’ This personalized approach recently showed its promise: Beekman’s group found a unique combination of five different drugs that caused the organoids from a particular patient to swell. ‘The swollen organoids told us that we had found a solution with which this patient’s life-threatening disease could suddenly be treated.’ This person has now access to this unique treatment and has shown tremendous improvement in clinical symptoms.
Speeding up this process: support and funding
The initial use of organoids is a remarkable milestone, with mini organs now incorporated into CF healthcare guidelines. What lessons can we glean from this pioneering example, and how can we enhance the utility of cultured mini-organs in biomedical research?
“I believe we need to further professionalize the infrastructure required for this research and integrate it with complementary technologies,” states Beekman. “Firstly, we must attract and value specialists who are essential for developing breeding technologies and are willing to invest the necessary years of effort to ensure their success. Additionally, support from funding agencies and policy is crucial.”
“This support is currently underway. For example, UMC Utrecht has made specific investments in a center for living technologies, where disease modeling technologies are being developed in collaboration with Eindhoven, Wageningen, and Utrecht (EWUU). Recently, UMCU has also joined other academic centers in the Institute for Human Organ and Disease Model Technologies (hDMT). This collaboration facilitates the development of disease models that offer insights into the human body’s response to therapy.”
“Moreover, funding from the Dutch Organization for Scientific Research (NWO) will establish a national infrastructure to support studies on organ and disease models using stem cells. The Dutch National Growth Fund (NGF) has pledged 124.5 million euros to establish the Centre for Animal-Free Biomedical Translation (CPBT), aimed at promoting animal-free biomedical innovations such as human cell models. These advancements promise safer and more effective treatments for patients while reducing animal suffering.”
This coordinated effort aims to elevate the capabilities of organoid research and expand its applications in advancing medical science.
Speeding up this process: applying AI
The Regenerative Medicine Center Utrecht is distinguished by its interdisciplinary community of researchers, constantly pioneering new paths. One innovative approach to developing and refining disease models is through the application of artificial intelligence (AI).
“We employ deep learning in conjunction with microscopy imaging to identify complex features within organoids that may not be discernible to the naked eye. These organoids could reveal critical characteristics that might otherwise go unnoticed, offering valuable insights into disease prediction, for instance.”
Faster, bigger and more detail
Sam van Beuningen, assistant professor in Jeffrey Beekman’s group, leverages AI to enhance organoid assays: “We employ deep learning in conjunction with microscopy imaging to identify complex features within organoids that may not be discernible to the naked eye. These organoids could reveal critical characteristics that might otherwise go unnoticed, offering valuable insights into disease prediction, for instance.”
AI also holds promise in potentially replacing fluorescent labels. “We’re exploring whether AI can accurately segment cells and organoids,” Van Beuningen explains. “This capability would eliminate the need for multiple fluorescent labels. Not only would this save researchers considerable lab work, but it would also extend assay durations, allowing for more comprehensive assessments of drug effects on organoids.”
According to Van Beuningen, their exploration of AI is just beginning: “The potential is immense, with applications spanning various fields. We’re collaborating extensively to leverage shared insights across experiments and tests involving imaging, whether it’s organoid assays, biofabrication, diagnostic imaging, or experiment automation. It’s an exciting journey to see where this integration will lead us.”


